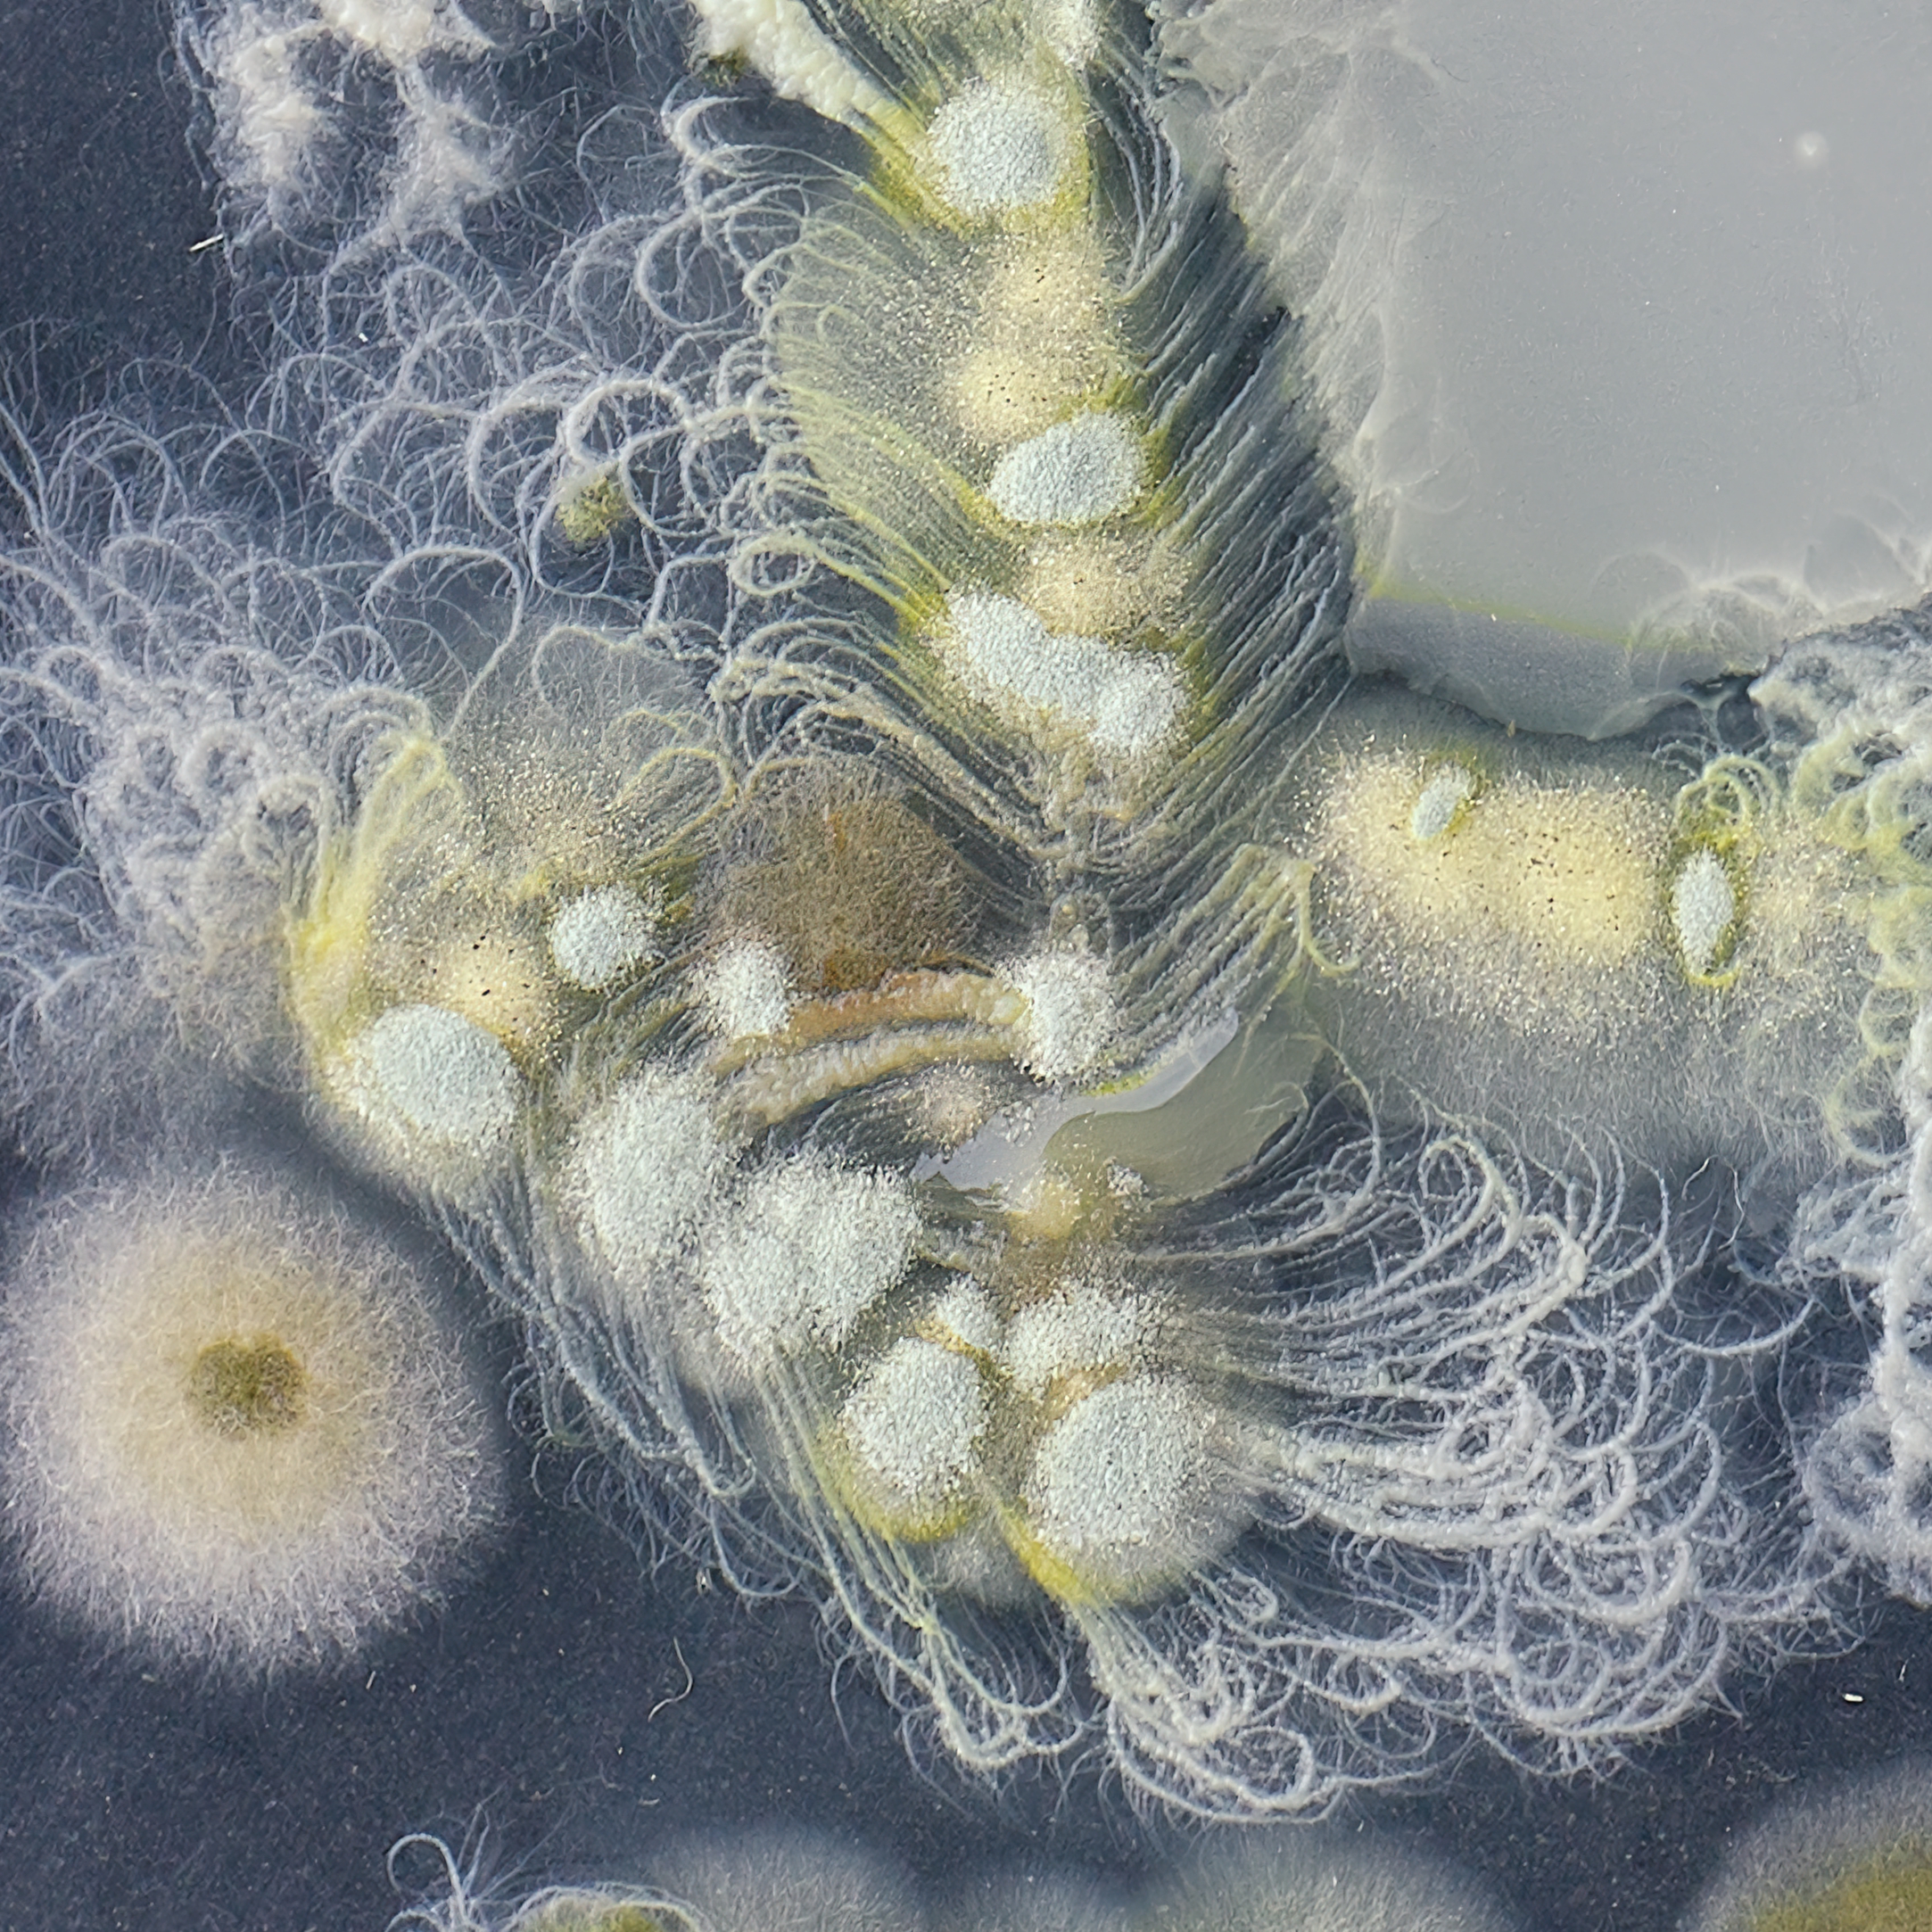
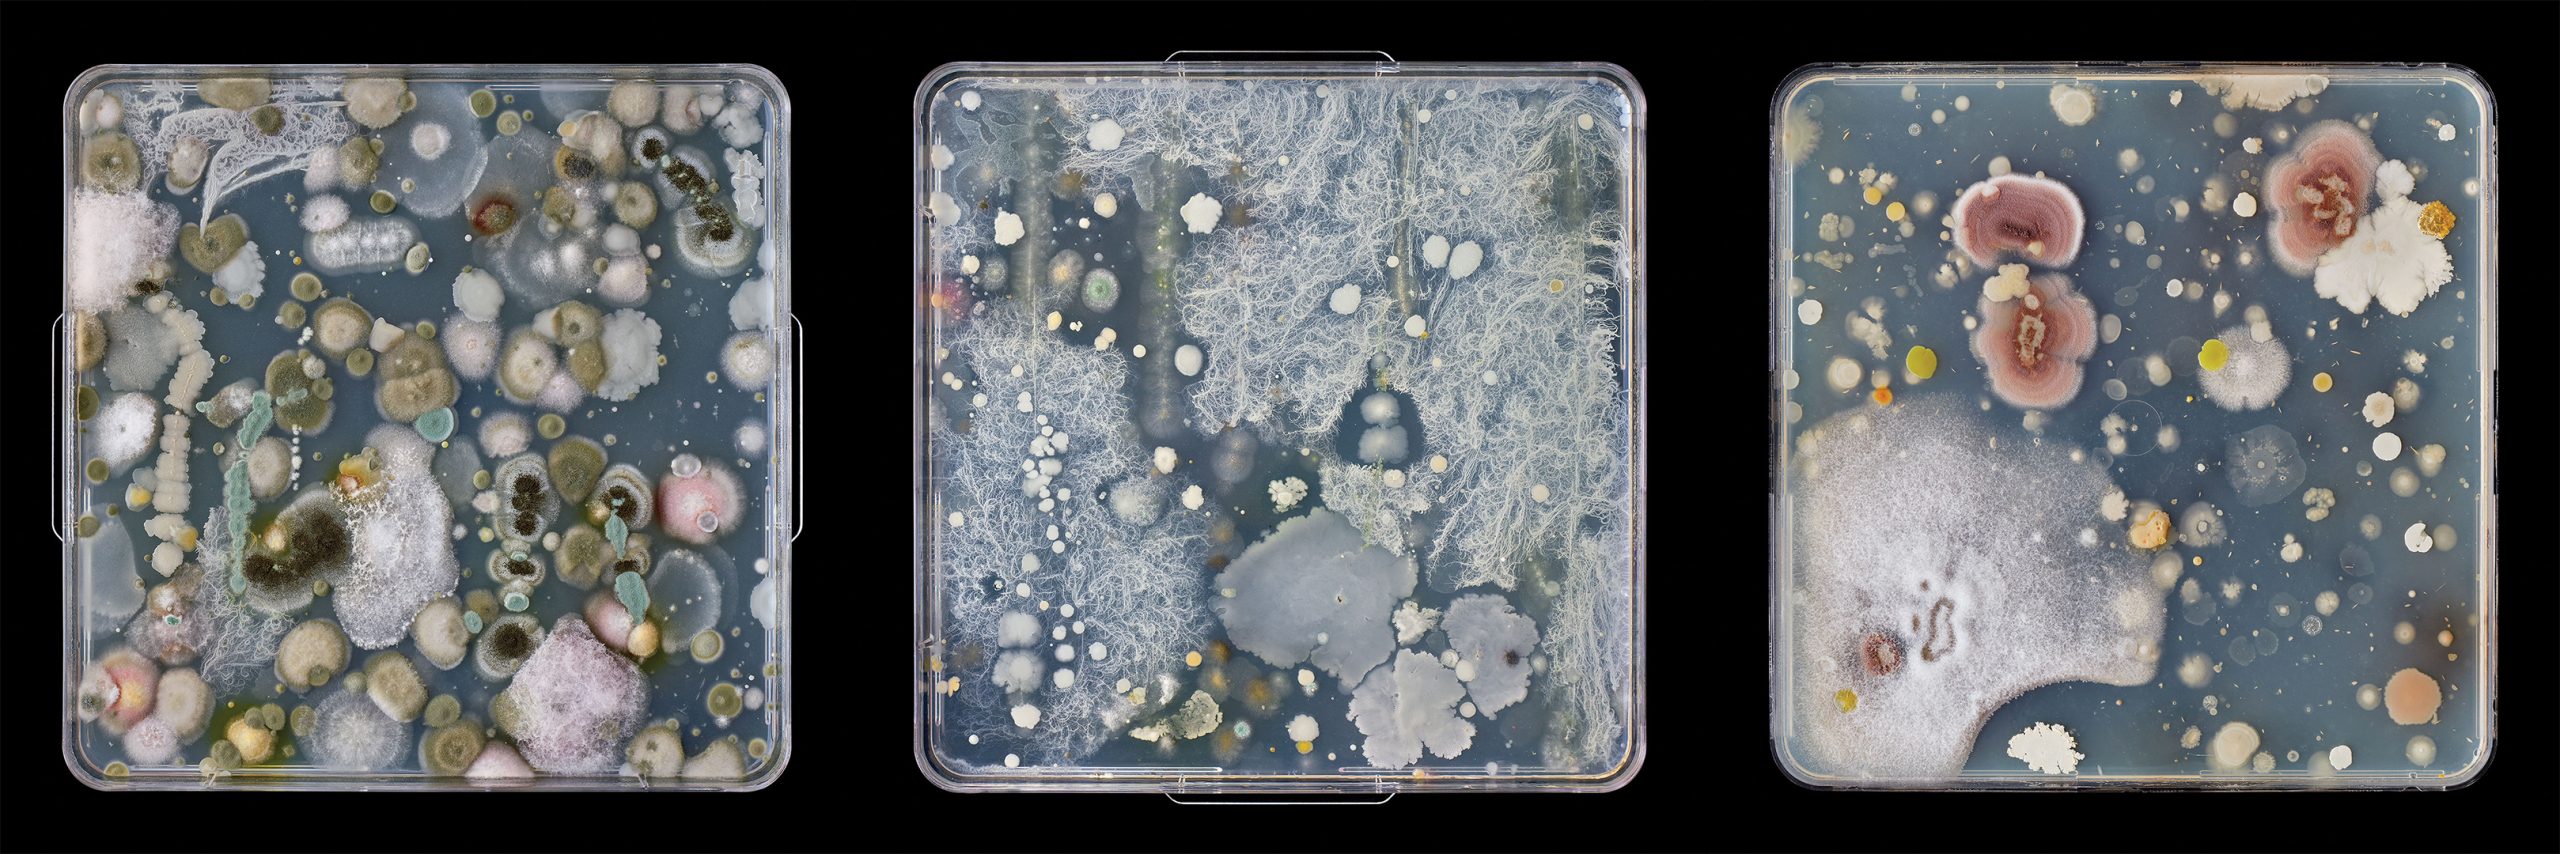

Jon Sasaki: Homage

Jon Sasaki: Homage
June 14, 2021 – January 13, 2022*
About the Exhibition
Jon Sasaki: Homage is a suite of photographs depicting petri dishes with bloomed bacterial cultures derived from swabs of the palettes and brushes used by members of the Group of Seven and Tom Thomson, objects held in the archives of the McMichael Canadian Art Collection. These large-scale works are monumental in scale yet they reveal microscopic detail, affirming a playful reverence towards the Group’s legacy while reframing the genre of landscape painting through the lens of photography. Through these glowing bacterial landscapes Sasaki has generated a new sublime, a counterpoint to the quotidian nature of what lies beneath. The artifacts from which the microscopic organisms were gathered will be exhibited in dialogue with the photographs, presenting a poignant entanglement of past and present-day artists in the story of Canadian art.
For media inquiries and more information, please visit the Press Room.
*Jon Sasaki: Homage has been extended by popular request until Thursday, January 13, 2022. Please be aware that the Founders’ Lounge, where the exhibition is on view, may be closed on certain dates due to private events.
Celebrating the Group of Seven with Jon Sasaki
May 7, 2021

Included in General Admission
Adult – $18
Senior – $15
25 and under – $5